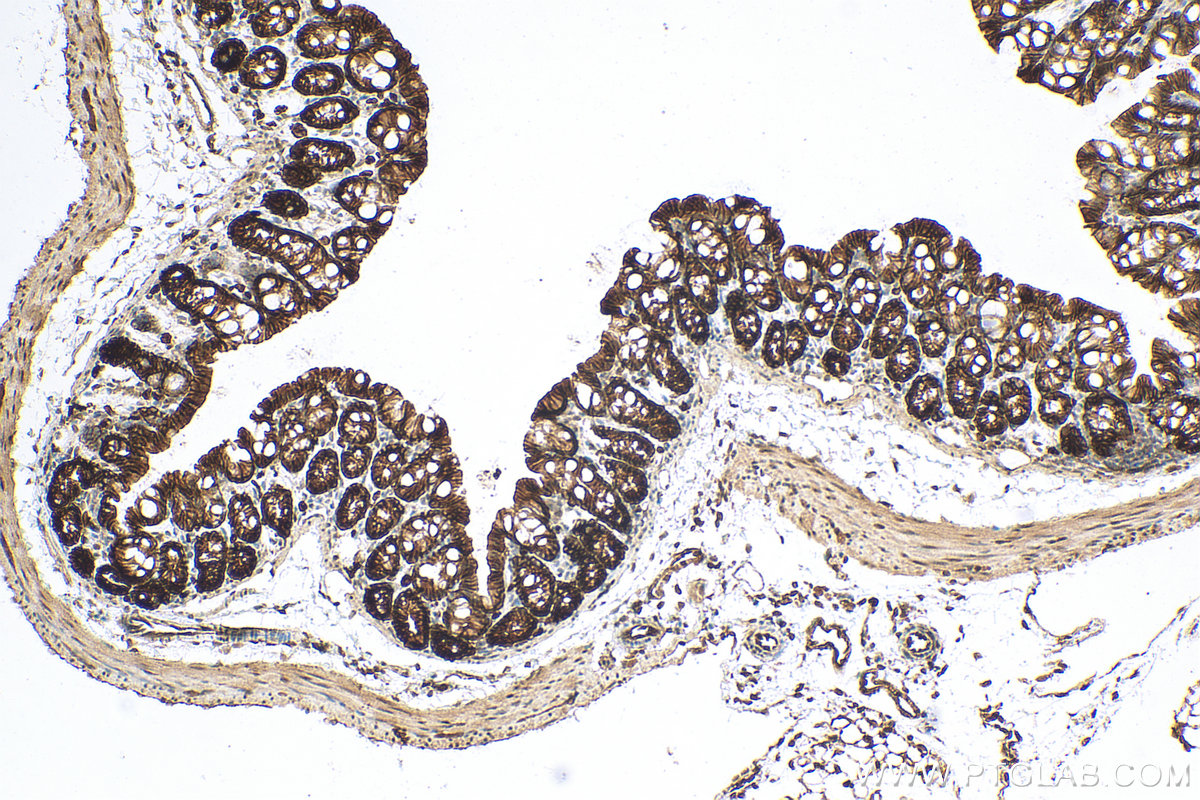
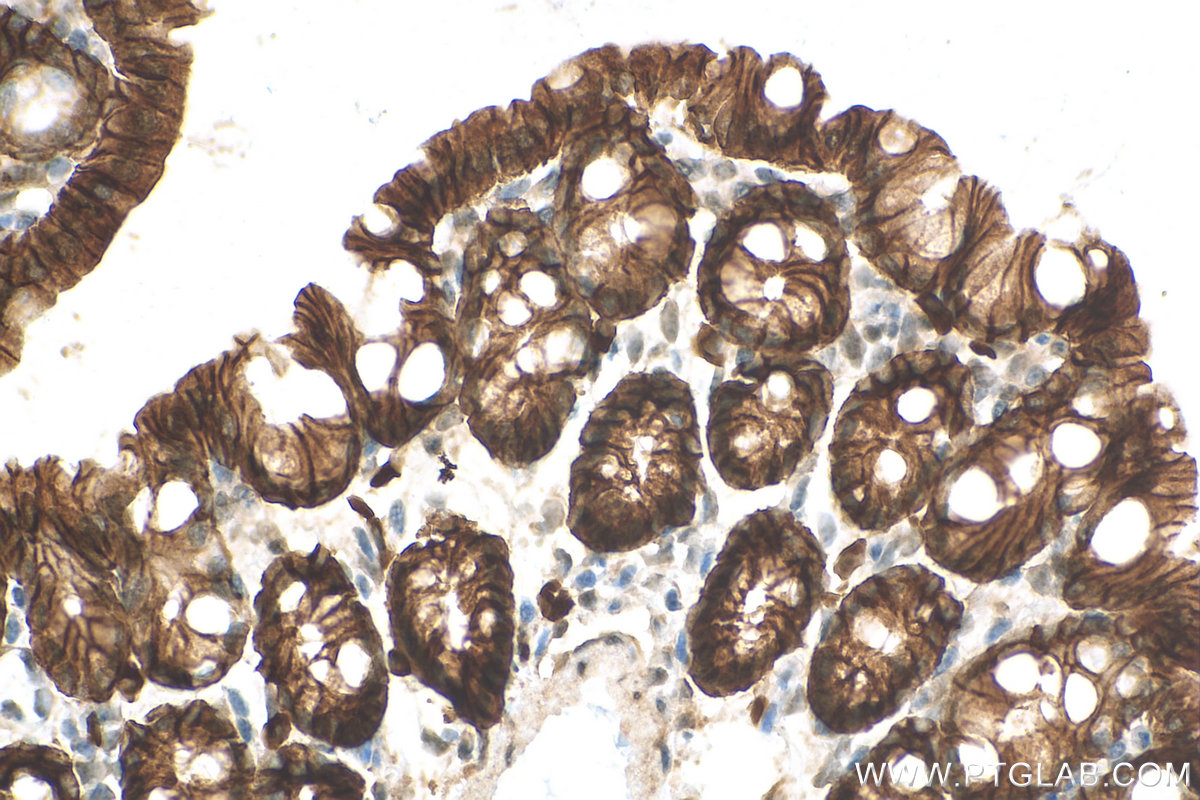

验证数据展示
经过测试的应用
| Positive WB detected in | A431 cells, mouse colon tissue, rat colon tissue |
| Positive IHC detected in | human colon cancer tissue, mouse colon tissue, human breast cancer tissue, human colon tissue, mouse stomach tissue Note: suggested antigen retrieval with TE buffer pH 9.0; (*) Alternatively, antigen retrieval may be performed with citrate buffer pH 6.0 |
| Positive IF-P detected in | mouse colon tissue, MCF-7 cells, mouse lung tissue |
| Positive IF-Fro detected in | mouse colon tissue |
| Positive IF/ICC detected in | HT-29 cells, MCF-7 cells |
| Positive FC detected in | HT-29 cells |
推荐稀释比
| 应用 | 推荐稀释比 |
|---|---|
| Western Blot (WB) | WB : 1:2000-1:10000 |
| Immunohistochemistry (IHC) | IHC : 1:500-1:2000 |
| Immunofluorescence (IF)-P | IF-P : 1:500-1:2000 |
| Immunofluorescence (IF)-FRO | IF-FRO : 1:200-1:800 |
| Immunofluorescence (IF)/ICC | IF/ICC : 1:50-1:500 |
| Flow Cytometry (FC) | FC : 0.50 ug per 10^6 cells in a 100 µl suspension |
| It is recommended that this reagent should be titrated in each testing system to obtain optimal results. | |
| Sample-dependent, Check data in validation data gallery. | |
产品信息
21050-1-AP targets EPCAM/CD326 in WB, IHC, IF/ICC, IF-P, IF-Fro, FC, IP, chIP, ELISA applications and shows reactivity with human, mouse, rat samples.
| 经测试应用 | WB, IHC, IF/ICC, IF-P, IF-Fro, FC, ELISA Application Description |
| 文献引用应用 | WB, IHC, IF, FC, IP, chIP |
| 经测试反应性 | human, mouse, rat |
| 文献引用反应性 | human, mouse, rat, pig, canine |
| 免疫原 |
CatNo: Ag15393 Product name: Recombinant human EPCAM protein Source: e coli.-derived, PGEX-4T Tag: GST Domain: 24-264 aa of BC014785 Sequence: QEECVCENYKLAVNCFVNNNRQCQCTSVGAQNTVICSKLAAKCLVMKAEMNGSKLGRRAKPEGALQNNDGLYDPDCDESGLFKAKQCNGTSTCWCVNTAGVRRTDKDTEITCSERVRTYWIIIELKHKAREKPYDSKSLRTALQKEITTRYQLDPKFITSILYENNVITIDLVQNSSQKTQNDVDIADVAYYFEKDVKGESLFHSKKMDLTVNGEQLDLDPGQTLIYYVDEKAPEFSMQGL 种属同源性预测 |
| 宿主/亚型 | Rabbit / IgG |
| 抗体类别 | Polyclonal |
| 产品类型 | Antibody |
| 全称 | epithelial cell adhesion molecule |
| 别名 | EPCAM, Adenocarcinoma-associated antigen, CD326, Cell surface glycoprotein Trop-1, CO 17A |
| 计算分子量 | 314 aa, 35 kDa |
| 观测分子量 | 35-40 kDa |
| GenBank蛋白编号 | BC014785 |
| 基因名称 | EPCAM |
| Gene ID (NCBI) | 4072 |
| RRID | AB_10693684 |
| 偶联类型 | Unconjugated |
| 形式 | Liquid |
| 纯化方式 | Antigen affinity purification |
| UNIPROT ID | P16422 |
| 储存缓冲液 | PBS with 0.02% sodium azide and 50% glycerol, pH 7.3. |
| 储存条件 | Store at -20°C. Stable for one year after shipment. Aliquoting is unnecessary for -20oC storage. |
背景介绍
Epithelial cell adhesion molecule (EpCAM, CD326) is a type I transmembrane glycoprotein that functions as a homophilic, epithelial-specific intercellular cell-adhesion molecule. In addition to cell adhesion, EpCAM is also involved in cellular signaling, cell migration, proliferation, and differentiation. EpCAM is highly expressed on most carcinomas and therefore of potential use as a diagnostic and prognostic marker for a variety of carcinomas, and has become a therapeutic target. EpCAM may occur in distinct forms due to glycosylation. (PMID: 20837599; 19249674; 21576002; 22647938; 12691820)
实验方案
| Product Specific Protocols | |
|---|---|
| FC protocol for EPCAM/CD326 antibody 21050-1-AP | Download protocol |
| IF protocol for EPCAM/CD326 antibody 21050-1-AP | Download protocol |
| IHC protocol for EPCAM/CD326 antibody 21050-1-AP | Download protocol |
| WB protocol for EPCAM/CD326 antibody 21050-1-AP | Download protocol |
| Standard Protocols | |
|---|---|
| Click here to view our Standard Protocols |
发表文章
| Species | Application | Title |
|---|---|---|
Mol Cancer m6A methylation reader IGF2BP2 activates endothelial cells to promote angiogenesis and metastasis of lung adenocarcinoma | ||
Cell Metab Nicotinamide metabolism face-off between macrophages and fibroblasts manipulates the microenvironment in gastric cancer | ||
Cancer Cell Loss of Lkb1 and Pten leads to lung squamous cell carcinoma with elevated PD-L1 expression. | ||
Gut Cross-talk between the gut microbiota and monocyte-like macrophages mediates an inflammatory response to promote colitis-associated tumourigenesis. | ||
Autophagy Neutrophil-derived serine proteases induce FOXA2-mediated autophagy dysfunction and exacerbate colitis-associated carcinogenesis via F2RL1/protease-activated receptor 2 |